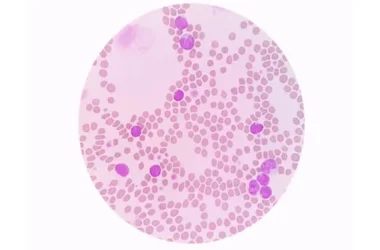

يعد ألم العصب الوركي، المعروف باسم عرق النسا، من الحالات المؤرقة التي تسبب إزعاجًا كبيرًا للكثيرين. هذا الألم الحاد الذي يمتد من أسفل الظهر إلى الساق يمكن أن يؤثر سلبًا على جودة الحياة اليومية.
في ظل البحث عن حلول فعالة، يتجه البعض نحو الطب البديل والتكميلي. فهل يمكن علاج العصب الوركي بالحجامة؟ دعنا نتعمق في فهم هذه العلاجات وإمكاناتها.
جدول المحتويات
- فهم العصب الوركي وعرق النسا
- الحجامة وعلاج العصب الوركي: كيف تعمل؟
- هل الحجامة فعالة لتخفيف آلام العصب الوركي؟
- خيارات علاجية أخرى للعصب الوركي
- خاتمة
فهم العصب الوركي وعرق النسا
يُعد العصب الوركي العصب الأكبر في جسم الإنسان، وينشأ من خمسة جذور عصبية تتحد في أسفل العمود الفقري. يمتد هذا العصب بعمق عبر الأرداف وأسفل المؤخرة وصولًا إلى الكعب والقدم.
أما “عرق النسا” أو التهاب العصب الوركي، فهو مصطلح يشير إلى الألم الناتج عن تهيج أو انضغاط في هذا العصب. يتسبب عادةً في ألم يمتد من أسفل الظهر لينتشر إلى الورك والأرداف والساق، مما يسبب إحساسًا بالوخز أو الخدر أو حتى الضعف.
الحجامة وعلاج العصب الوركي: كيف تعمل؟
إلى جانب العلاجات الطبية التقليدية مثل الكورتيزون ومضادات الالتهاب ومرخيات العضلات، يبحث الكثيرون عن علاجات تكميلية. تُعد الحجامة من الممارسات العلاجية القديمة التي يفضلها البعض لتخفيف آلام العصب الوركي.
الأسس العلمية لعمل الحجامة
تعتمد الحجامة على مبدأ الشفط الموضعي، حيث تُوضع كؤوس خاصة على الجلد لإنشاء ضغط سلبي. يُعتقد أن هذا الإجراء يساعد الجسم في عدة جوانب:
- زيادة تدفق الدم: يعمل الشفط على جذب الدم إلى المنطقة المستهدفة، مما يعزز الدورة الدموية ويساعد في توصيل الأكسجين والمغذيات.
- تخفيف الضغط: يمكن للحجامة أن تساعد في تقليل الضغط على العصب الوركي من خلال إرخاء العضلات المحيطة به، مما يفسح له المجال للاستقرار والتعافي.
- إرخاء العضلات: تسهم عملية الشفط في تفكيك العقد العضلية وتخفيف التشنجات، مما يقلل من الضغط الميكانيكي على العصب.
- إزالة السموم: تُعزى بعض فوائد الحجامة إلى قدرتها على المساعدة في إزالة الفضلات الخلوية المحتبسة أو السموم من المنطقة المعالجة، مما يحسن وظيفة العصب.
تُستخدم الحجامة أيضًا بشكل عام لتخفيف آلام الظهر والرقبة وتيبس العضلات، بالإضافة إلى المساهمة في تهدئة الجهاز العصبي وتقليل القلق والإرهاق.
أنواع الحجامة المستخدمة
تشمل الحجامة نوعين رئيسيين: الحجامة الجافة (بدون تشريط) والحجامة الرطبة (بالتشريط). يُعتقد أن الحجامة الرطبة بشكل خاص تساعد في إزالة أي فضلات خلوية أو مواد عالقة في منطقة العصب الوركي قد تعيق وظيفته الطبيعية.
هل الحجامة فعالة لتخفيف آلام العصب الوركي؟
بناءً على الآليات المذكورة، تشير العديد من التجارب الشخصية ومراجعات بعض الدراسات إلى أن الحجامة قد تقدم فوائد ملموسة في تخفيف آلام العصب الوركي. يمكن أن يساهم تأثيرها في تحسين الدورة الدموية وإرخاء العضلات وتقليل الالتهاب في تسكين الألم.
مع ذلك، من المهم الإشارة إلى أن الأبحاث العلمية حول فعالية الحجامة في علاج العصب الوركي بالحجامة لا تزال قيد التوسع. ينبغي دائمًا استشارة أخصائي رعاية صحية لتقييم حالتك وتحديد خطة العلاج الأنسب لك.
خيارات علاجية أخرى للعصب الوركي
بجانب الحجامة، توجد عدة علاجات بديلة وتكميلية يمكن أن تساعد في تخفيف آلام العصب الوركي:
التمارين الرياضية والإطالة
تلعب التمارين الرياضية الخفيفة وتمارين الإطالة دورًا حاسمًا في إدارة آلام عرق النسا. يساعد تقوية عضلات الظهر والعضلات الأساسية في دعم العمود الفقري وتقليل الضغط على العصب الوركي.
عند الشعور بتحسن، يمكنك الانتقال تدريجيًا إلى تمارين أكثر قوة، ولكن استمع دائمًا إلى جسدك وتجنب أي حركات تزيد الألم.
العلاج بالتدليك (المساج)
يقدم العلاج بالتدليك فوائد جمة لتخفيف آلام العصب الوركي. فهو يقلل من تهيج المسار العصبي ويخفف الألياف العضلية المحيطة بالعصب، مما يقلل الضغط عليه.
يزيد التدليك أيضًا من تدفق الدم إلى المناطق المتضررة، مما يسرع عملية الشفاء. يعتبر التدليك وسيلة وقائية فعالة، خاصة للحوامل في الثلث الثالث وراكبي الدراجات والعدائين المعرضين لعرق النسا المزمن.
الوخز بالإبر الصينية
يُعرف الوخز بالإبر كطريقة مسكنة فعالة ومثبتة للعديد من الآلام المزمنة والاضطرابات. في سياق العصب الوركي، يقدم الوخز بالإبر الفوائد التالية:
- يُعتقد أنه يحفز الألياف العصبية المتضررة لفترة قصيرة، مما يقلل من انتقال إشارات الألم إلى الدماغ.
- ينشط آليات المسكنات الذاتية في الجسم، مما يحفز إفراز الإندورفين ويطلق الأدينوزين، وينتج عنه تأثير مسكن سريع وفعال.
أشارت دراسات، مثل تلك التي أجريت على جذور الأعصاب الفقرية، إلى انخفاض فوري وملحوظ في أعراض عرق النسا بعد الوخز بالإبر. كما أظهرت التجارب على الحيوانات أن الوخز بالإبر قد يكون علاجًا واعدًا لتجديد الأعصاب الوركية التالفة.
خاتمة
في الختام، يمثل ألم العصب الوركي تحديًا صحيًا يؤثر على جودة الحياة. لقد استعرضنا إمكانية علاج العصب الوركي بالحجامة كخيار ضمن الطب التكميلي، حيث تظهر آلياته القدرة على تخفيف الألم عبر تحسين تدفق الدم وإرخاء العضلات.
تذكر أن هذا المقال يقدم معلومات عامة. للحصول على تشخيص دقيق وخطة علاج مناسبة، يجب دائمًا استشارة طبيب أو أخصائي رعاية صحية مؤهل. يمكن لاتباع نهج شامل يشمل العلاجات الطبية، والتمارين، والتدليك، والوخز بالإبر أن يساعدك في إدارة هذه الحالة بفعالية.